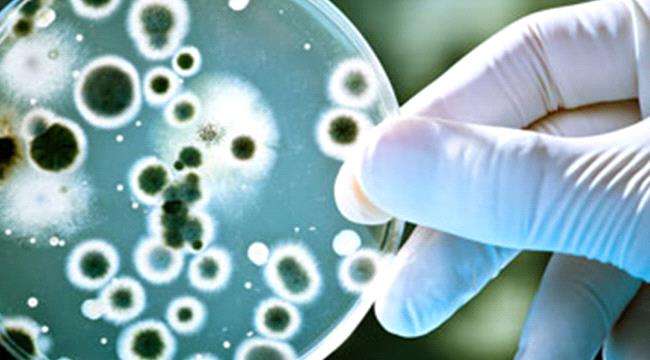

الفيروسات تستخدم أسلوبا فريدا لمتابعة ما يجري في الجسم البشري
توصل بحث جديد إلى أن الفيروسات تستخدم المعلومات المستمدة من بيئتها لتقرر متى تظل في وضع السكون، دون نشاط يذكر داخل مضيفها، ومتى تتكاثر وتنفجر، ما يؤدي إلى قتل الخلية المضيفة.
في الوقت الحالي، تستغل الفيروسات القدرة على مراقبة بيئتها لصالحها، ولكن في المستقبل، يرجح الفريق البحثي أن البشر سيمكنهم استغلال بيانات الفيروسات حول بيئتها الخاصة لإلحاق الضرر بها.
وركزت الدراسة الجديدة على العاثيات، وهي فيروسات تصيب البكتيريا، حيث لا يمكن أن تصيب العاثيات في الدراسة مضيفيها إلا عندما تكون للخلايا البكتيرية زوائد خاصة، تسمى الشعيرة والسوط، وهي التي تساعد البكتيريا على الحركة والتزاوج.
وتنتج البكتيريا بروتينًا يسمى CtrA، يتحكم في وقت تكوين هذه الزوائد، وتُظهر الورقة البحثية الجديدة أن العديد من العاثيات التي تعتمد على الملاحق لها أنماط في حمضها النووي، حيث يمكن لبروتين CtrA أن يلتصق، وتسمى مواقع الربط، ويشير الفريق البحثي إلى أن العاثية التي لها موقع ربط لبروتين ينتجه مضيفها أمر غير معتاد.
والأكثر إثارة للدهشة، أن الفريق توصل من خلال التحليل الجينومي المفصل إلى أن مواقع الربط لم تكن فريدة من نوعها لعاثية واحدة، أو حتى مجموعة واحدة من العاثيات، فالعديد من الأنواع المختلفة من العاثيات تحتوي على مواقع ربط CtrA، لكنها جميعًا طلبت من مضيفيها أن يكون لديهم سوط pili لإصابتها، وقرروا أن الأمر لا يمكن أن يكون مصادفة.
وقال إيفان إيريل، بروفيسور العلوم البيولوجية في جامعة ماريلاند في مقاطعة بالتيمور، إن القدرة على مراقبة مستويات CtrA ”تم اختراعها عدة مرات خلال التطور بوساطة عاثيات مختلفة تصيب بكتيريا مختلفة“.
وعندما تُظهر الأنواع ذات الصلة البعيدة سمة مماثلة، فإنها تسمى التطور المتقارب، وهي تشير إلى أن السمة مفيدة بالتأكيد.
وحدد فريق البحث مواقع ارتباط CtrA تصيب مجموعة معينة من البكتيريا تسمى Caulobacterales Caulobacterales، وهي مجموعة من البكتيريا تمت دراستها جيدًا ، لأنها توجد في شكلين: شكل ”سرب“ يسبح بحرية، وشكل ”مطارد“ يلتصق بالسطح.
فالأسراب لها شعيرة أو سوط، بينما السيقان ليست كذلك، وفي هذه البكتيريا، ينظم CtrA أيضًا دورة الخلية، ويحدد ما إذا كانت الخلية ستقسم بالتساوي إلى خليتين أخريين من نفس نوعها، أو تنقسم بشكل غير متماثل لإنتاج سرب واحد وخلية ساق واحدة.
ونظرًا لأن العاثيات يمكنها إصابة خلايا السرب فقط، فمن مصلحتها فقط أن تنفجر من مضيفها عندما يكون هناك العديد من الخلايا السربية المتاحة للإصابة.
وبشكل عام، تعيش Caulobacterales في بيئات تفتقر المغذيات، وهي منتشرة بشكل كبير.
وقال إيريل ”لكن عندما تجد جيبًا جيدًا من الموائل الدقيقة، فإنها تتحول إلى خلايا مطاردة وتتكاثر“، ما ينتج في النهاية كميات كبيرة من الخلايا الحاشدة.
وأضاف: ”نفترض أن العاثيات تراقب مستويات CtrA، التي ترتفع وتنخفض خلال دورة حياة الخلايا، لمعرفة متى تصبح خلية السرب خلية ساق، وتصبح مصنعًا للأسراب“.
وتابع: ”عند هذه النقطة، تقوم بتفجير الخلية، لأنه سيكون هناك العديد من الأسراب القريبة للإصابة“.
وحسب إيريل، فإن النتيجة الرئيسة من هذا البحث هي أن ”الفيروس يستخدم الذكاء الخلوي لاتخاذ القرارات، وإذا كان يحدث في البكتيريا، فمن شبه المؤكد أنه يحدث في النباتات والحيوانات، لأنها إذا كانت إستراتيجية تطورية منطقية، سوف يكتشفها التطور ويستغلها“.
وعلى سبيل المثال، لتحسين إستراتيجيته للبقاء والتكاثر، قد يرغب فيروس حيواني في معرفة نوع النسيج الموجود فيه، أو مدى قوة الاستجابة المناعية للمضيف للعدوى، في حين إنه قد يكون من المقلق التفكير في جميع فيروسات المعلومات التي يمكن أن تجمعها وربما تستخدمها لجعلنا أكثر مرضًا، فإن هذه الاكتشافات تفتح أيضًا طرقًا لعلاجات جديدة.
وقال إيريل: ”إذا كنت تطور دواءً مضادًا للفيروسات، وكنت تعلم أن الفيروس يستمع إلى إشارة معينة، فربما يمكنك خداع الفيروس“.
وأضاف: ”بدأنا للتو في إدراك مدى فعالية تركيز الفيروسات علينا – كيف تراقب ما يجري حولها وتتخذ قرارات بناءً على ذلك.. ومستقبلًا سنتمكن من استخدام تلك البيانات لتطوير عقاقير علاجية تنجح في القضاء عليها“.